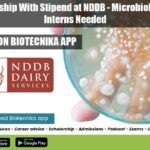
Freshers Internship at NDDB

Home Search
microbiology - search results
If you're not happy with the results, please do another search
Summer Training Programme 2022 at ICMR-NIRRCH, Apply Online
Summer Training Programme 2022 at ICMR-NIRRCH, Apply Online
Summer Training Programme 2022 at ICMR-NIRRCH, Apply Online. Summer Training 2022 India. MSc & MTech Summer Training...
ICAR-Directorate of Weed Research Young Professional Recruitment
ICAR-DWR Jobs For Biotech, Biochem, Botany and Microbiology
ICAR-DWR Jobs For Biotech, Biochem, Botany and Microbiology. BSc Biotechnology/ Biochemistry/Botany/Plant Physiology/Microbiology Young professional job opening at...
Biotecnika Times Newsletter 04.02.2022 UPSC IFS Exam 2022, 15+ Freshers Govt Internship
Biotecnika Times - UPSC IFS Exam 2022, 15+ Freshers Govt Internship
UPSC IFS Exam 2022 – Indian Forest Service Exam 2022 Application, Eligibility
The application is...
CSIR-NCL Project Associate Recruitment, Online Application Process
CSIR-NCL Pune PhD Job - Project Associate Recruitment
CSIR-NCL Pune PhD Job - Project Associate Recruitment. NCL Pune is hiring PhD candidates for project positions....
Freshers Internship With Stipend at NDDB – Microbiological Analysis Interns Needed
Freshers Internship at NDDB - Microbiological Analysis Interns Needed
Freshers Internship at NDDB - Microbiological Analysis Interns Needed. Intern-Microbiological Analysis Vacancies at National Dairy Development...
ICMR-RMRCNE Project Scientist & SRF Recruitment, Applications Invited
ICMR-RMRCNE Project Scientist & SRF Recruitment, Applications Invited
ICMR-RMRCNE Project Scientist & SRF Recruitment, Applications Invited. Life Sciences / Biotechnology / Microbiology / Molecular Biology...
Project JRF Post For MSc & MTech Life Sciences at RCB, Apply Online
RCB Faridabad Research Jobs For MSc & MTech Life Sciences
RCB Faridabad Research Jobs For MSc & MTech Life Sciences. MSc/MTech Life Sciences/ Biotechnology/ Molecular...
PI Industries Hiring For Research Scientist Biology, Apply Online
PI Industries Biology Research Scientist Job Opening
PI Industries Biology Research Scientist Job Opening. MSc Biology, Molecular Biology, Biochemistry and Microbiology job opening. Research Scientist...
Government ILS Life Sciences Senior Research Fellow Recruitment
Government ILS Life Sciences Senior Research Fellow Recruitment
Government ILS Life Sciences Senior Research Fellow Recruitment. MSc life sciences, biotech, biochem, microbiology and bioinformatics candidates...
Biotecnika Newsletter 01.02.2022 Hiring Research Intern, NIPER PhD Admission, CIAB
Biotecnika Times - Hiring Research Intern, NIPER PhD Admission, CIAB
Research Intern Recruitment at Zero Meat – Online Application Process
Research Intern Recruitment at Zero Meat...
ICMR-National Institute of Virology Non-Medical Project Scientist Job With Rs. 67,000 pm Pay
ICMR-NIV Project Scientist Job Opening With Rs. 67,000 pm Salary
ICMR-NIV Project Scientist Job Opening With Rs. 67,000 pm Salary. Virology jobs. Microbiology jobs in...
Govt ILS Bhubaneswar PhD Life Sciences Research Associate Recruitment
Govt ILS Bhubaneswar PhD Life Sciences Research Associate Recruitment
Govt ILS Bhubaneswar PhD Life Sciences Research Associate Recruitment. PhD life sciences candidates apply for RA...
Research Intern Recruitment at Zero Meat – Online Application Process
Research Intern Recruitment at Zero Meat - Online Application Process
Research Intern Recruitment at Zero Meat - Online Application Process. Zero Meat Internship. Research Internship...
ICMR-NIRT Project Consultant Microbiologist Vacancy With Rs. 65,000 pm Pay
ICMR-NIRT Project Consultant Microbiologist Vacancy With Rs. 65,000 pm Pay
ICMR-NIRT Project Consultant Microbiologist Vacancy With Rs. 65,000 pm Pay. MSc/ PhD Microbiology, Project Consultant...
Pachhunga University College JRF Vacancy For MSc Life Sciences
Pachhunga University College JRF Vacancy For MSc Life Sciences
Pachhunga University College JRF Vacancy For MSc Life Sciences. MSc Life Sciences, Biotechnology, Microbiology, Biochemistry, Molecular...